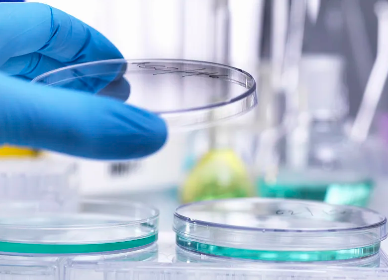
image.png

哪家醫(yī)院在干細(xì)胞移植倉(cāng)領(lǐng)域領(lǐng)先?
2024-10-25 11:28:50 來(lái)源: 小編 咨詢醫(yī)生
干細(xì)胞移植技術(shù)作為一種前沿的生物治療方法,近年來(lái)在醫(yī)學(xué)領(lǐng)域取得了顯著的進(jìn)展。本文將為您詳細(xì)介紹在干細(xì)胞移植倉(cāng)領(lǐng)域領(lǐng)先的醫(yī)院,并探討其在技術(shù)創(chuàng)新、臨床應(yīng)用及科研等方面的優(yōu)勢(shì)。
干細(xì)胞移植倉(cāng)技術(shù)簡(jiǎn)介
干細(xì)胞移植倉(cāng)是一種用于干細(xì)胞移植的無(wú)菌、恒溫、恒濕的專用房間。在這個(gè)環(huán)境中,干細(xì)胞可以在最適宜的條件下生長(zhǎng)、繁殖,為患者提供高質(zhì)量的移植細(xì)胞。干細(xì)胞移植倉(cāng)技術(shù)在我國(guó)已經(jīng)取得了長(zhǎng)足的發(fā)展,許多醫(yī)院在這一領(lǐng)域取得了顯著的成果。
哪家醫(yī)院在干細(xì)胞移植倉(cāng)領(lǐng)域領(lǐng)先?
1.北京大學(xué)第一醫(yī)院
北京大學(xué)第一醫(yī)院是我國(guó)干細(xì)胞移植領(lǐng)域的佼佼者。醫(yī)院擁有一支專業(yè)的干細(xì)胞移植團(tuán)隊(duì),具備豐富的臨床經(jīng)驗(yàn)和技術(shù)實(shí)力。在干細(xì)胞移植倉(cāng)建設(shè)方面,醫(yī)院引進(jìn)了國(guó)際先進(jìn)的設(shè)備和技術(shù),為患者提供了高質(zhì)量的干細(xì)胞移植服務(wù)。
2.上海交通大學(xué)醫(yī)學(xué)院附屬瑞金醫(yī)院
瑞金醫(yī)院在干細(xì)胞移植領(lǐng)域具有較高的知名度。醫(yī)院擁有一流的干細(xì)胞移植倉(cāng)設(shè)施,嚴(yán)格遵循國(guó)際標(biāo)準(zhǔn),為患者提供安全、有效的干細(xì)胞移植治療。此外,瑞金醫(yī)院在干細(xì)胞移植技術(shù)的研發(fā)和臨床應(yīng)用方面取得了諸多突破。
3.中山大學(xué)附屬第一醫(yī)院
中山大學(xué)附屬第一醫(yī)院在干細(xì)胞移植倉(cāng)領(lǐng)域具有明顯優(yōu)勢(shì)。醫(yī)院擁有一支專業(yè)的干細(xì)胞移植團(tuán)隊(duì),開展了多項(xiàng)國(guó)內(nèi)外領(lǐng)先的干細(xì)胞移植技術(shù)。在干細(xì)胞移植倉(cāng)建設(shè)方面,醫(yī)院秉持高標(biāo)準(zhǔn)、嚴(yán)要求,為患者提供了優(yōu)質(zhì)的醫(yī)療服務(wù)。
4.浙江大學(xué)醫(yī)學(xué)院附屬第一醫(yī)院
浙江大學(xué)醫(yī)學(xué)院附屬第一醫(yī)院在干細(xì)胞移植領(lǐng)域具有豐富的臨床經(jīng)驗(yàn)和技術(shù)積累。醫(yī)院擁有一流的干細(xì)胞移植倉(cāng)設(shè)施,為患者提供了舒適的就醫(yī)環(huán)境。此外,醫(yī)院在干細(xì)胞移植技術(shù)的研發(fā)和推廣方面取得了顯著成果。
總結(jié)
在干細(xì)胞移植倉(cāng)領(lǐng)域,上述幾家醫(yī)院均具有明顯的領(lǐng)先地位。它們?cè)诩夹g(shù)創(chuàng)新、臨床應(yīng)用及科研等方面取得了顯著成果,為我國(guó)干細(xì)胞移植事業(yè)的發(fā)展做出了重要貢獻(xiàn)。隨著干細(xì)胞移植技術(shù)的不斷成熟和普及,相信未來(lái)將有更多患者受益于這一**性的生物治療方法。
-
上一頁(yè): 濰坊哪家干細(xì)胞醫(yī)院口碑最佳?
-
下一頁(yè): 國(guó)內(nèi)哪家干細(xì)胞醫(yī)院知名度最高?
- 2024-07-23吉美干細(xì)胞醫(yī)院,吉美干細(xì)胞是正規(guī)品牌嗎
- 2024-11-29湖南干細(xì)胞存儲(chǔ)公司排名,權(quán)威榜單揭曉
- 2024-11-29廣州干細(xì)胞修復(fù)專業(yè)醫(yī)院有哪些,專業(yè)水準(zhǔn)如何評(píng)估
- 2024-09-13山東莒縣捐贈(zèng)干細(xì)胞機(jī)構(gòu)有哪些,內(nèi)附名單表
- 2024-10-10干細(xì)胞海河醫(yī)院治療成果如何?一文揭秘
- 2024-11-05福建省干細(xì)胞存儲(chǔ)哪家機(jī)構(gòu)口碑好?如何選擇存儲(chǔ)服務(wù)?
- 2024-07-18干細(xì)胞移植治療帕金森的費(fèi)用大概多少,干細(xì)胞治療帕金森的效果費(fèi)用介紹
- 2024-10-10海免疫干細(xì)胞作用大嗎?如何發(fā)揮其潛力?
- 2024-09-06廣東牙髓干細(xì)胞功效及臨床應(yīng)用
- 2024-07-18干細(xì)胞能治愈肝硬化嗎,干細(xì)胞對(duì)肝硬化的作用和功效
- 2024-08-06間充質(zhì)干細(xì)胞治療,間充質(zhì)干細(xì)胞治療的原理
- 2024-09-10深圳做干細(xì)胞免疫機(jī)構(gòu)排名榜單
- 2024-09-05多能干細(xì)胞技術(shù)治療原理,帶你揭開它的神秘面紗
- 2024-09-27干細(xì)胞治療真的存在騙局嗎,如何辨別有效性
- 2024-09-27貝拉醫(yī)療門診部(廣州)怎么樣
- 2024-10-11干細(xì)胞的醫(yī)療功效,影響治療效果的3個(gè)要素
- 2024-10-09造血干細(xì)胞可以分化成什么細(xì)胞,關(guān)鍵因素是什么?
- 2024-08-08蘋果干細(xì)胞是什么功效,蘋果干細(xì)胞真能美容嗎
